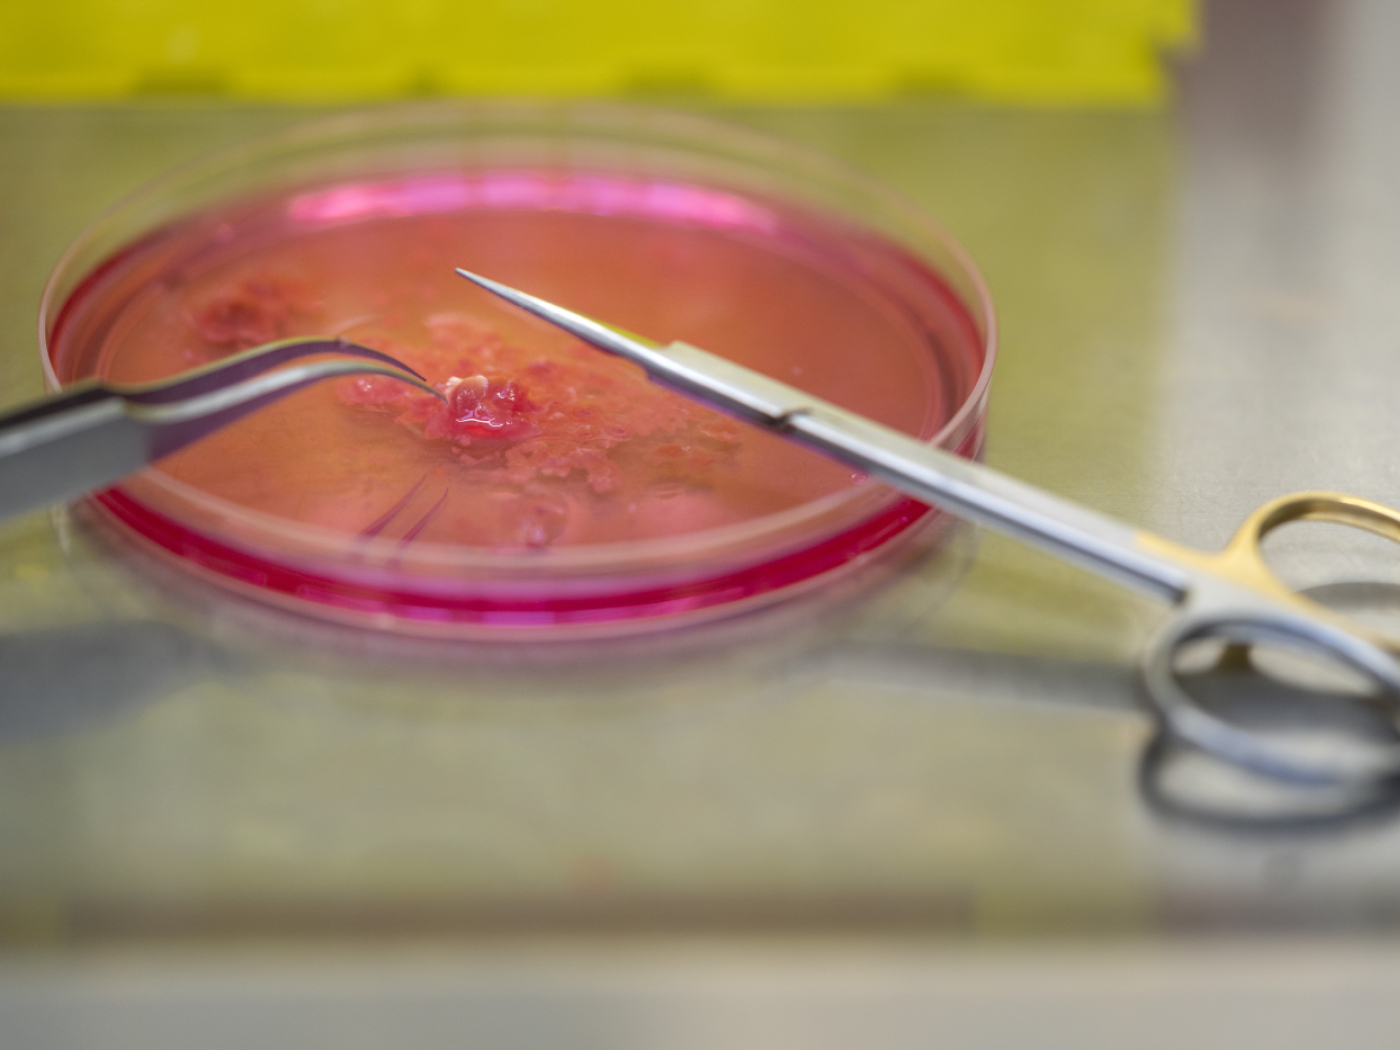

Berner Netzwerk fördert Entwicklung von neuen Lebensmitteln
Im Raum Bern können Start-ups und kleine Firmen bei der Entwicklung von Lebensmitteln auf ein neues Netzwerk zurückgreifen. Der AgroFoodPark unterstützt die Unternehmen von der ersten Idee bis zur Markteinführung.
(Keystone-SDA) Das teilte die Berner Hochschule für Agrar-, Forst- und Lebensmittelwissenschaften (BFH-HAFL) am Freitag mit. Sie hat das Netzwerk zusammen mit dem Nahrungsmittelhersteller Haco sowie Sproudz und RegioFood Hub geschaffen. Beide unterstützen Innovationen in der Lebensmittelbranche.
«Viele Betriebe haben zukunftsweisende Ideen, scheitern aber an technologischen und fachlichen Herausforderungen», wurde Ursula Kretzschmar von der BFH-HAFL in der Mitteilung zitiert. Für das Netzwerk stellt die Hochschule fachliches Knowhow, Laborkapazitäten und Pilotanlagen zur Verfügung. Die Idee bleibt immer Eigentum der Firma.
Ein Beispiel ist ein Start-up, das Hummus aus Lupinen herstellt. Die Hochschule hilft, den bitteren Geschmack zu verringern und den Herstellungsprozess zu verbessern. Kleine Mengen werden in Testküchen produziert und von Kunden ausprobiert. Bei Erfolg übernimmt Haco die industrielle Produktion.
Der AgroFoodPark stärke die Innovationskraft der regionalen Wirtschaft und schaffe Arbeitsplätze, hiess es im Communiqué.








